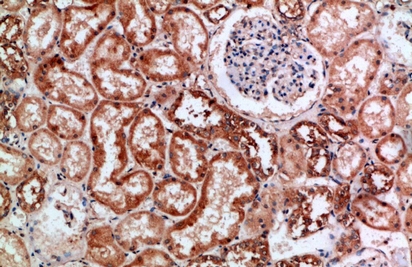
product-image-AAA173917_IHC13.jpg

2'- Deoxyguanosine- 3', 5'- cyclic monophosphate (2'-dcGMP) Biochemical
2'- Deoxyguanosine- 3', 5'- cyclic monophosphate (2'-dcGMP)
Purity
Typical analysis is better than 98% (HPLC /UV/ 252 nm). The product is not sterile and has not been tested for endotoxins.
Synonyms
2'- Deoxyguanosine- 3', 5'- cyclic monophosphate (2'-dcGMP); N/A; 2'- Deoxyguanosine- 3', 5'- cyclic monophosphate (2'-dcGMP) biochemical
Specificity
Lyophilized or crystallized sodium salt. The free acid or other saltforms of 2'-dcGMP are available upon request. Please keep in mind that equal concentrations of the compound may look different in volumedue to sensitivity of the lyophilized form to humidity. The compound can even contract to small volume droplets. Normally the product is located in the conical bottom of the tube. Micromolar quantities are determined by UV at λ max.
Purity/Purification
Typical analysis is better than 98% (HPLC /UV/ 252 nm). The product is not sterile and has not been tested for endotoxins.
Formula
C10H11N5O6P.Na
UV
λmax 252nm / ε 13500 / pH 7
Properties
Due to its lacking 2'-hydroxy group 2'-dcGMP can be useful for cGMP receptor mapping studies. Receptor proteins which need e.g. hydrogen bonds to recognize cyclic GMP at the 2' ribose part, will show considerably reduced binding affinity. 2'-dcGMP is, for example, an rather inactive control at cGMP-dependent protein kinases, for which an intact 2'-OH group is essentially required.
Solubility
2'-dcGMP is readily soluble in water or buffers. Please rinse tube walls carefully and preferably use ultrasonic or vortex to achieve total and uniform mixing. When opening the tube please make sure that no substance is lost within the cap.
Preparation and Storage
2'-dcGMP is chemically stable under conditions of biological systems and media. Nevertheless, we recommend that the compound should be stored in the freezer, for longer storage periods preferably in freeze-dried form.
Related Product Information for 2'- Deoxyguanosine- 3', 5'- cyclic monophosphate (2'-dcGMP) biochemical
2'-dcGMP is an analogue of the natural signal molecule cyclic GMP in whichthe 2'-hydroxy group in the ribose moiety is lacking.
Customer Reviews
Loading reviews...
Share Your Experience
Similar Products
Product Notes
The 2'- Deoxyguanosine- 3', 5'- cyclic monophosphate (2'-dcGMP) (Catalog #AAA52687) is a Biochemical and is intended for research purposes only. The product is available for immediate purchase. It is sometimes possible for the material contained within the vial of "2'- Deoxyguanosine- 3', 5'- cyclic monophosphate (2'-dcGMP), Biochemical" to become dispersed throughout the inside of the vial, particularly around the seal of said vial, during shipment and storage. We always suggest centrifuging these vials to consolidate all of the liquid away from the lid and to the bottom of the vial prior to opening. Please be advised that certain products may require dry ice for shipping and that, if this is the case, an additional dry ice fee may also be required.Precautions
All products in the AAA Biotech catalog are strictly for research-use only, and are absolutely not suitable for use in any sort of medical, therapeutic, prophylactic, in-vivo, or diagnostic capacity. By purchasing a product from AAA Biotech, you are explicitly certifying that said products will be properly tested and used in line with industry standard. AAA Biotech and its authorized distribution partners reserve the right to refuse to fulfill any order if we have any indication that a purchaser may be intending to use a product outside of our accepted criteria.Disclaimer
Though we do strive to guarantee the information represented in this datasheet, AAA Biotech cannot be held responsible for any oversights or imprecisions. AAA Biotech reserves the right to adjust any aspect of this datasheet at any time and without notice. It is the responsibility of the customer to inform AAA Biotech of any product performance issues observed or experienced within 30 days of receipt of said product. To see additional details on this or any of our other policies, please see our Terms & Conditions page.Item has been added to Shopping Cart
If you are ready to order, navigate to Shopping Cart and get ready to checkout.